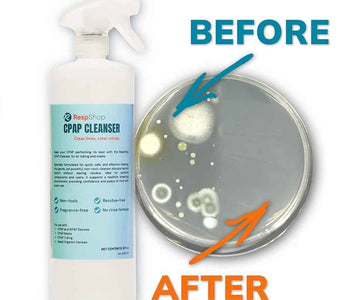

Introducing the RespShop CPAP Cleanser: A Safe and Effective Cleaning Solution
If you’ve been following along, you might have seen that we recently launched our very first product: the RespShop CPAP Cleanser! This has been an exciting journey for us, and I wanted to take a moment to dive deeper into what makes this cleanser special, how it works, and even share some of my personal experiences using it.
What’s in the RespShop CPAP Cleanser?
Our formula is simple but powerful. It contains only three ingredients:
• Electrolyzed Water
• Sodium Chloride (salt)
• Pure Hypochlorous Acid (HOCl)
Now, let’s talk about the star of the show—Hypochlorous Acid. You may have heard of it before, as it’s an FDA-approved compound used widely in medical and healthcare settings. It’s 100 times stronger than bleach when it comes to killing bacteria, yet it’s completely safe for everyday use.
I know what you might be thinking: “Wait, stronger than bleach? That doesn’t sound safe for my CPAP equipment!” I had the same initial thought, but here’s the key difference—Hypochlorous Acid is non-toxic, non-irritating, and safe for human contact. It’s commonly found in skincare products, nasal sprays, mouthwashes, and even wound care solutions. While I wouldn’t recommend drinking it, you can confidently use it to clean your CPAP gear without worrying about harsh chemicals.
Plus, it’s fragrance-free, which is a big win for those with allergies or sensitivities to artificial scents. When applied, you might notice a faint chlorine-like smell, but don’t worry—it disappears quickly. That subtle scent is simply an indication that the compound is actively breaking down bacteria and contaminants.
How to Use the RespShop CPAP Cleanser
CPAP equipment requires regular cleaning to function properly and last longer. Over time, dust, bacteria, and moisture build up inside masks, hoses, and machines, affecting both performance and hygiene. That’s where our cleanser comes in.
Here’s how to use it:
• Masks & Machines: Spray a fine mist directly onto the surface. You can either let it air-dry or wipe it off after 30 seconds. This ensures the solution has enough time to effectively eliminate germs.
• Hoses & Tubing: Remove the top, fill the hose about one-third of the way, and swish the solution around for about 30 seconds. Then, pour it out and let it air-dry completely before reattaching it to your CPAP device.
• Headgear & Accessories: Give straps, cushions, and humidifier chambers a quick spray and allow them to dry naturally.
Why is regular CPAP cleaning so important?
Many CPAP users have different cleaning routines. Some wash their equipment daily, while others might only clean it once a week or even once a month. No matter how often you clean, studies have shown that keeping your CPAP equipment sanitized prevents bacteria from breaking down the materials, preserving the integrity of seals and airflow components. This not only extends the lifespan of your gear but also improves your overall sleep quality by reducing exposure to dust, mold, and allergens.
Beyond CPAP: Everyday Uses for the RespShop Cleanser
One of the things that excites me most about this product is how versatile it is! While we designed it specifically for CPAP equipment, I’ve been experimenting with it in my everyday life, and the results have been impressive.
Here are a few surprising ways I’ve used it:
• Desk & Workspace Cleaning: Like many of us, I spend a lot of time at my desk, and it tends to accumulate coffee stains, dust, and germs. I sprayed the cleanser on my desk, wiped it down, and it left everything clean and residue-free—with no lingering smell!
• Shoe Odor Removal: I had heard that Hypochlorous Acid works well for neutralizing odors, so I decided to put it to the test. I sprayed some into an old pair of running shoes that had been sitting in my closet for months. After letting them dry, I checked back, and the smell was completely gone!
• Cleaning Workout Gear: I own a weighted vest that I use for walks with my dogs, and it’s notoriously hard to clean. Since it can’t be thrown in the washing machine, I would usually have to soak it—an inconvenient and time-consuming process. Instead, I used the RespShop Cleanser on it daily for two weeks and was amazed that there were no lingering sweat odors, no new stains, and no visible wear and tear. It felt as fresh as the day I bought it!
I keep finding new ways to use this spray, and I’d love to hear from you! If you’ve already tried the RespShop CPAP Cleanser and have found unique ways to use it outside of CPAP equipment, let us know!
Why We Created This Cleanser
At RespShop, our mission has always been to provide high-quality CPAP solutions that help you breathe easier and sleep better. We saw a need for a safe, effective, and affordable cleaning solution, and that’s exactly what we set out to create. The RespShop CPAP Cleanser is free of harsh chemicals, fragrances, and unnecessary additives, making it a simple yet powerful way to keep your equipment clean.
If you haven’t given it a try yet, we highly encourage you to check it out! We’re confident that once you see how easy and effective it is, you’ll wonder how you ever managed your CPAP routine without it.
Final Thoughts
Proper CPAP hygiene plays a major role in ensuring the longevity of your equipment and the quality of your sleep. With the RespShop CPAP Cleanser, you can easily incorporate a quick and effective cleaning routine that fits your lifestyle. And beyond CPAP care, it’s a handy tool for everyday cleaning needs—whether it’s freshening up your workspace, neutralizing odors, or maintaining workout gear.
We’d love to hear how you use the RespShop CPAP Cleanser! Share your experiences with us, and if you have any questions, feel free to reach out. Happy cleaning!